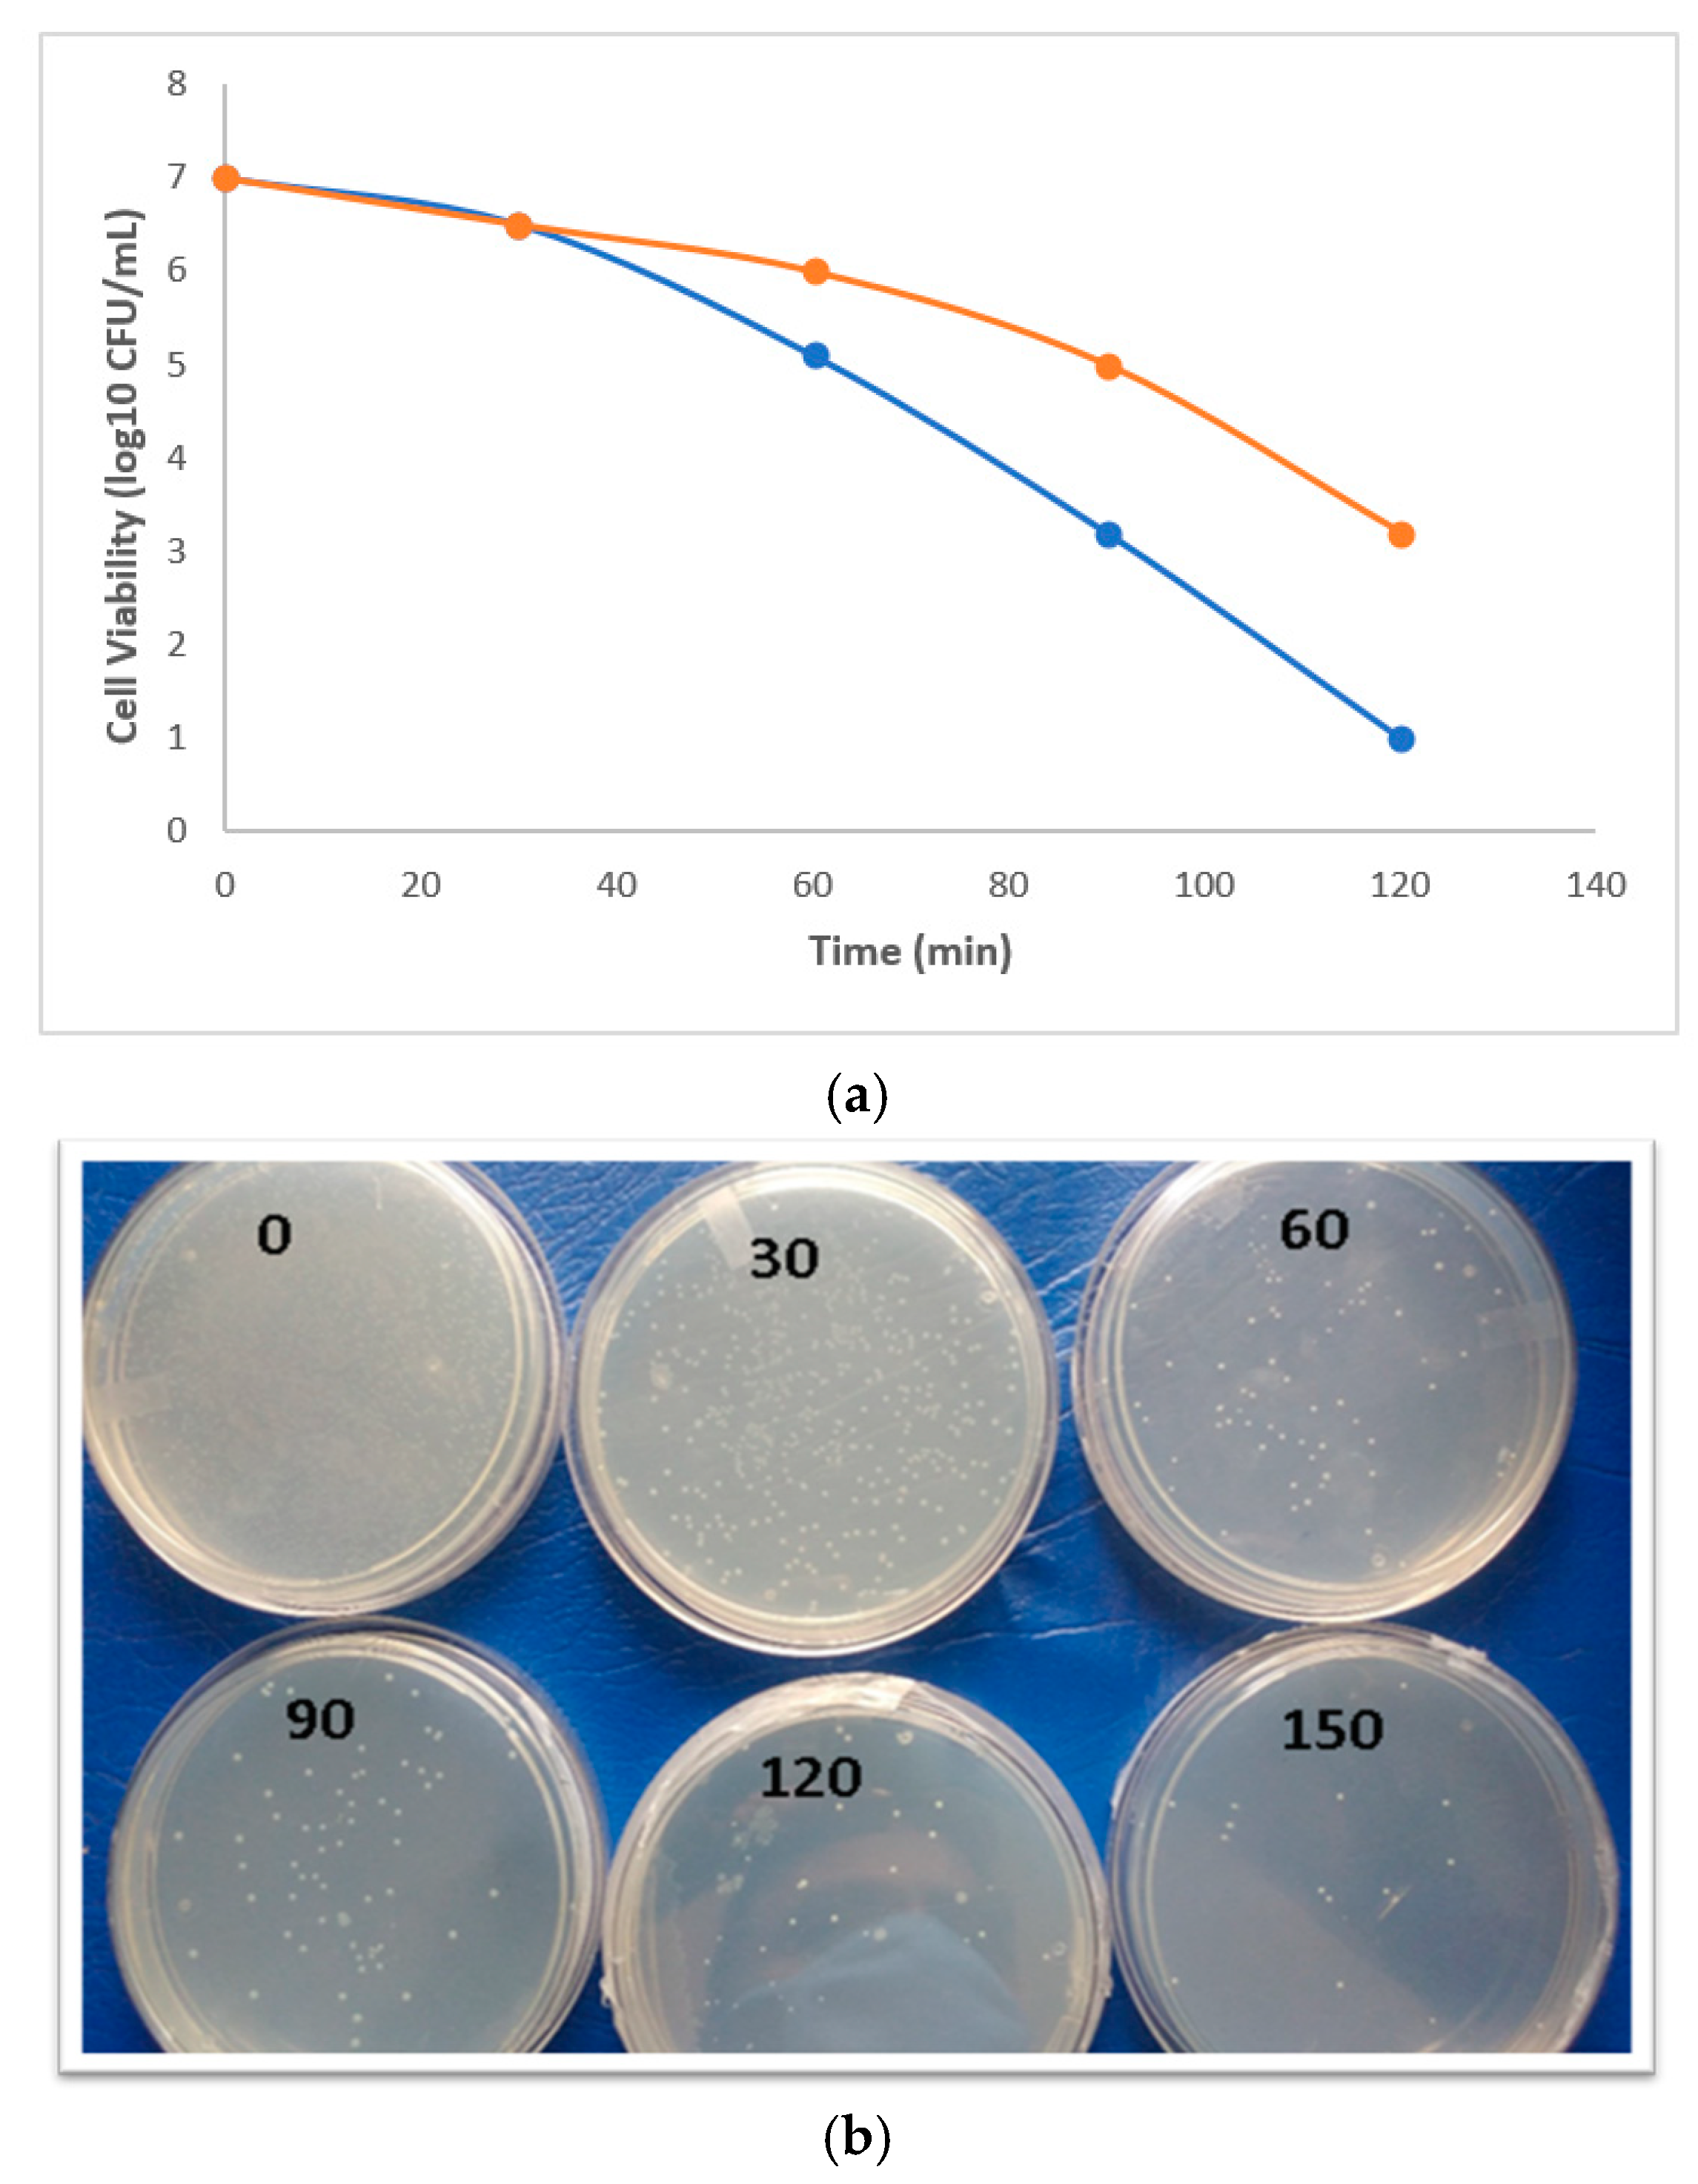
Biomolecules 11 00190 g009 Biomolecules 11 00190 g009

Phytogenic Synthesis of Pd-Ag/rGO Nanostructures Using Stevia Leaf Extract for Photocatalytic H2 Production and Antibacterial Studies
Abstract
1. Introduction
2. Materials and Methods
2.1. Preparation of Graphene Oxide (GO)
2.2. Preparation of Pd-Ag/Reduced Graphene Oxide (rGO) and Pd/rGO
2.3. Characterization
2.4. Photocatalytic Hydrogen Evaluation
2.5. Antimicrobial Activity of Pd/Ag/rGO
3. Results
3.1. UV-Visible Analysis
3.2. XRD Analysis
3.3. FTIR Analysis
3.4. TEM Analysis
3.5. XPS Analysis
3.6. Hydrogen Production
3.7. Antimicrobial Activity of Pd/Ag/rGO
4. Conclusions
Author Contributions
Funding
Institutional Review Board Statement
Informed Consent Statement
Data Availability Statement
Conflicts of Interest
References
- Khataee, A.R.; Kasiri, M.B. Photocatalytic degradation of organic dyes in the presence of nanostructured titanium dioxide: Influence of the chemical structure of dyes. J. Mol. Catal. A Chem. 2010, 328, 8–26. [Google Scholar] [CrossRef]
- Kuriakose, S.; Satpati, B.; Mohapatra, S. Highly efficient photocatalytic degradation of organic dyes by Cu doped ZnO nanostructures. Phys. Chem. Chem. Phys. 2015, 17, 25172–25181. [Google Scholar] [CrossRef] [PubMed]
- Veerasamy, R.; Xin, T.Z.; Gunasagaran, S.; Xiang, T.F.W.; Yang, E.F.C.; Jeyakumar, N.; Dhanaraj, S.A. Biosynthesis of silver nanoparticles using mangosteen leaf extract and evaluation of their antimicrobial activities. J. Saudi Chem. Soc. 2011, 15, 113–120. [Google Scholar] [CrossRef]
- Xie, G.; Zhang, K.; Guo, B.; Liu, Q.; Fang, L.; Gong, J.R. Graphene-Based Materials for Hydrogen Generation from Light-Driven Water Splitting. Adv. Mater. 2013, 25, 3820–3839. [Google Scholar] [CrossRef]
- Wang, P.; Zhan, S.; Xia, Y.; Ma, S.; Zhou, Q.; Li, Y. The fundamental role and mechanism of reduced graphene oxide in rGO/Pt-TiO2 nanocomposite for high-performance photocatalytic water splitting. Appl. Catal. B Environ. 2017, 207, 335–346. [Google Scholar] [CrossRef]
- Zeng, X.; Wang, Z.; Meng, N.; McCarthy, D.T.; Deletic, A.; Pan, J.; Zhang, X. Highly dispersed TiO2 nanocrystals and carbon dots on reduced graphene oxide: Ternary nanocomposites for accelerated photocatalytic water disinfection. Appl. Catal. B Environ. 2017, 202, 33–41. [Google Scholar] [CrossRef]
- Jiao, Z.; Zhang, Y.; Ouyang, S.; Yu, H.; Lu, G.; Ye, J.; Bi, Y. BiAg Alloy Nanospheres: A New Photocatalyst for H2 Evolution from Water Splitting. ACS Appl. Mater. Interfaces 2014, 6, 19488–19493. [Google Scholar] [CrossRef]
- Meng, X.; Li, Z.; Chen, J.; Xie, H.; Zhang, Z. Enhanced visible light-induced photocatalytic activity of surface-modified BiOBr with Pd nanoparticles. Appl. Surf. Sci. 2018, 433, 76–87. [Google Scholar] [CrossRef]
- Jiang, T.; Qin, X.; Sun, Y.; Yu, M. UV photocatalytic activity of Au@ZnO core–shell nanostructure with enhanced UV emission. RSC Adv. 2015, 5, 65595–65599. [Google Scholar] [CrossRef]
- Gupta, J.; Bahadur, D. Visible Light Sensitive Mesoporous Cu-Substituted ZnO Nanoassembly for Enhanced Photocatalysis, Bacterial Inhibition, and Noninvasive Tumor Regression. ACS Sustain. Chem. Eng. 2017, 5, 8702–8709. [Google Scholar] [CrossRef]
- Vu, T.A.; Dao, C.D.; Hoang, T.T.T.; Dang, P.T.; Tran, H.T.K.; Nguyen, K.T.; Le, G.H.; Nguyen, T.V.; Lee, G.D. Synthesis of novel silver vanadates with high photocatalytic and antibacterial activities. Mater. Lett. 2014, 123, 176–180. [Google Scholar] [CrossRef]
- Bibi, I.; Kamal, S.; Ahmed, A.; Iqbal, M.; Nouren, S.; Jilani, K.; Nazar, N.; Amir, M.; Abbas, A.; Ata, S.; et al. Nickel nanoparticle synthesis using Camellia Sinensis as reducing and capping agent: Growth mechanism and photo-catalytic activity evaluation. Int. J. Biol. Macromol. 2017, 103, 783–790. [Google Scholar] [CrossRef] [PubMed]
- Kharissova, O.V.; Dias, H.R.; Kharisov, B.I.; Pérez, B.O.; Pérez, V.M.J. The greener synthesis of nanoparticles. Trends Biotechnol. 2013, 31, 240–248. [Google Scholar] [CrossRef] [PubMed]
- Das, R.K.; Pachapur, V.L.; Lonappan, L.; Naghdi, M.; Pulicharla, R.; Maiti, S.; Cledon, M.; Dalila, L.M.A.; Sarma, S.J.; Brar, S.K. Biological synthesis of metallic nanoparticles: Plants, animals and microbial aspects. Nanotechnol. Environ. Eng. 2017, 2, 1. [Google Scholar] [CrossRef]
- De Matteis, V.; Rizzello, L.; Ingrosso, C.; Liatsi-Douvitsa, E.; De Giorgi, M.L.; De Matteis, G.; Rinaldi, R. Cultivar-Dependent Anticancer and Antibacterial Properties of Silver Nanoparticles Synthesized Using Leaves of Different Olea Europaea Trees. Nanomaterials 2019, 9, 1544. [Google Scholar] [CrossRef]
- Meng, X.; Li, Z.; Zhang, Z. Palladium nanoparticles and rGO co-modified BiVO 4 with greatly improved visible light-induced photocatalytic activity. Chemosphere 2018, 198, 1. [Google Scholar] [CrossRef]
- Wang, B.; Chang, Y.; Zhi, L. High yield production of graphene and its improved property in detecting heavy metal ions. New Carbon Mater. 2011, 26, 31–35. [Google Scholar] [CrossRef]
- Wang, C.; Yue, R.; Wang, H.; Zou, C.; Du, J.; Jiang, F.; Du, Y.; Yang, P.; Wang, C. Dendritic Ag@Pt core–shell catalyst modified with reduced graphene oxide and titanium dioxide: Fabrication, characterization, and its photo-electrocatalytic performance. Int. J. Hydrogen Energy 2014, 39, 5764–5771. [Google Scholar] [CrossRef]
- Huang, Y.; Miao, Y.; Ji, S.; Tjiu, W.W.; Liu, T. Electrospun Carbon Nanofibers Decorated with Ag–Pt Bimetallic Nanoparticles for Selective Detection of Dopamine. ACS Appl. Mater. Interfaces 2014, 6, 12449–12456. [Google Scholar] [CrossRef]
- Yilmaz, M.; Turkdemir, H.; Kilic, M.A.; Bayram, E.; Cicek, A.; Mete, A.; Ulug, B. Biosynthesis of silver nanoparticles using leaves of Stevia rebaudiana. Mater. Chem. Phys. 2011, 130, 1195–1202. [Google Scholar] [CrossRef]
- Kumar, D.A.; Palanichamy, V.; Roopan, S.M. One step production of AgCl nanoparticles and its antioxidant and photo catalytic activity. Mater. Lett. 2015, 144, 62–64. [Google Scholar] [CrossRef]
- Prasad, K.; Lekshmi, G.S.; Ostrikov, K.; Lussini1, V.; Blinco1, J.; Mohandas, M.; Vasilev, K.; Bottle, S.; Bazaka1, K.; Ostrikov, K. Synergic bactericidal effects of reduced graphene oxide and silver nanoparticles against Gram-positive and Gram-negative bacteria. Sci. Rep. 2017, 7, 1–11. [Google Scholar] [CrossRef] [PubMed]
- Manikandan, V.; Velmurugana, P.; Parka, J.-H.; Lovanhc, N.; Seod, S.-K.; Jayanthi, P.; Parke, Y.-J.; Choa, M.; Oha, B.-K. Synthesis and antimicrobial activity of palladium nanoparticles from Prunus × yedoensis leaf extract. Mater. Lett. 2017. [Google Scholar] [CrossRef]
- Surendra, T.V.; Roopan, S.M.; Arasu, M.V.; Al-Dhabi, N.A.; Rayalu, G.M. RSM optimized Moringa oleifera peel extract for green synthesis of M. oleifera capped palladium nanoparticles with antibacterial and hemolytic property oleifera capped palladium nanoparticles with antibacterial and hemolytic property. J. Photochem. Photobiol. B 2016, 162, 550–557. [Google Scholar] [CrossRef]
- Tahir, K.; Nazir, S.; Li, B.; Khan, A.U.; Khan, Z.U.H.; Ahmad, A.; Khan, F.U. An efficient photo catalytic activity of green synthesized silver nanoparticles using Salvadora persica stem extract. Sep. Purif. Technol. 2015, 150, 316–324. [Google Scholar] [CrossRef]
- Reddy, T.; Kim, H. Facile synthesis of silver nanoparticles and its antibacterial activity against Escherichia coli and unknown bacteria on mobile phone touch surfaces/computer keyboards. Appl. Phys. A 2016, 122, 1–10. [Google Scholar] [CrossRef]
- Ajitha, B.; Reddy, Y.A.K.; Reddy, P.S. Green synthesis and characterization of silver nanoparticles using Lantana camara leaf extract. Mater. Sci. Eng. C 2015, 49, 373–381. [Google Scholar] [CrossRef]
- Singh, A.K.; Xu, Q. Synergistic Catalysis over Bimetallic Alloy Nanoparticles. ChemCatChem 2013, 5, 652–676. [Google Scholar] [CrossRef]
- Lingamdinne, L.P.; Lee, S.; Choi, J.-S.; Reddy, L.V.; et al. Potential of the magnetic hollow sphere nanocomposite (graphene oxide-gadolinium oxide) for arsenic removal from real field water and antimicrobial applications. J. Hazard. Mater. 2021. [Google Scholar] [CrossRef]
- Dhanavel, S.; Manivannan, N.; Mathivanan, N.; Gupta, V.K.; Narayanan, V.; Stephen, A. Preparation and characterization of cross-linked chitosan/palladium nanocomposites for catalytic and antibacterial activity. J. Mol. Liq. 2018, 257, 32–41. [Google Scholar] [CrossRef]
- Tahir, K.; Nazir, S.; Li, B.; Ahmad, A.; Nasir, T.; Khan, A.U.; Shah, S.A.A.; Khan, Z.U.H.; Yasin, G.; Hameed, M.U. Sapium sebiferum leaf extract mediated synthesis of palladium nanoparticles and in vitro investigation of their bacterial and photocatalytic activities. J. Photochem. Photobiol. B Biol. 2016, 164, 164–173. [Google Scholar] [CrossRef] [PubMed]
- Mallikarjuna, K.; Al-Mohaimeed, A.M.; Al, A.F.; Reddy, L.V.; Vasudeva Reddy, M.R.; Mohammed, A. Facile Synthesis, Characterization, Anti-Microbial and Anti-Oxidant Properties of Alkylamine Functionalized Dumb-Bell Shaped Copper-Silver Nanostructures. Crystals 2020, 10, 966. [Google Scholar] [CrossRef]
- Zhang, P.; Song, T.; Wang, T.; Zeng, H. Plasmonic Cu nanoparticle on reduced graphene oxide nanosheet support: An efficient photocatalyst for improvement of near-infrared photocatalytic H2 evolution. Appl. Catal. B Environ. 2018, 225, 172–179. [Google Scholar] [CrossRef]
- Jeeva, K.; Thiyagarajan, M.; Elangovan, V.; Geetha, N.; Venkatachalam, P. Caesalpinia coriaria leaf extracts mediated biosynthesis of metallic silver nanoparticles and their antibacterial activity against clinically isolated pathogens. Ind. Crops Prod. 2014, 52, 714–720. [Google Scholar] [CrossRef]
- Li, Y.; Song, Y.; Ma, Z.; Niu, S.; Li, J.; Li, N. Synthesis of phosphonic acid silver-graphene oxide nanomaterials with photocatalytic activity through ultrasonic-assisted method. Ultrason. Sonochem. 2018, 44, 106–114. [Google Scholar] [CrossRef] [PubMed]
- Bathinapatla, S.; Fernandes, D.M.; Ch, M.; Madhavi, G. Facile one pot synthesis of bimetallic Pd-Ag/reduced graphene oxide nanocomposite as an electrochemical sensor for sensitive detection of anti-hypotensive drug. Colloids Surf. A Physicochem. Eng. Asp. 2018, 546, 293–300. [Google Scholar] [CrossRef]
- Mallikarjuna, K.; Reddy, Y.V.M.; Sravani, B.; Madhavi, G.; Kim, H.; Agarwal, S.; Gupta, V.K. Simple synthesis of biogenic PdAg bimetallic nanostructures for an ultra-sensitive electrochemical sensor for sensitive determination of uric acid. J. Electroanal. Chem. 2018, 822, 163–170. [Google Scholar] [CrossRef]
- Kadi, M.W.; Mohamed, R.M. Preparation and characterization of Pt, N-TiO2-graphene nanocomposites for hydrogen production. Ceram. Int. 2019, 45, 6058–6065. [Google Scholar] [CrossRef]
- Bhavani, K.; Naresh, G.; Srinivas, B.; Venugopal, A. Plasmonic resonance nature of Ag-Cu/TiO2 photocatalyst under solar and artificial light: Synthesis, characterization and evaluation of H2O splitting activity. Appl. Catal. B Environ. 2016, 199, 282–291. [Google Scholar] [CrossRef]
- Ma, J.; Yu, X.; Liu, X.; Li, H.; Hao, X.; Li, J. The preparation and photocatalytic activity of Ag-Pd/g-C3N4 for the coupling reaction between benzyl alcohol and aniline. Mol. Catal. 2019, 476, 110533. [Google Scholar] [CrossRef]
- Holt, K.B.; Bard, A.J. Interaction of silver (I) ions with the respiratory chain of Escherichia coli: An electrochemical and scanning electrochemical microscopy study of the antimicrobial mechanism of micromolar Ag+. Biochemistry 2005, 44, 13214–13223. [Google Scholar] [CrossRef] [PubMed]
- Tahir, K.; Nazir, S.; Ahmad, A.; Li, B.; Shah, S.A.A.; Khan, A.U.; Khan, G.M.; Khan, Q.U.; Khan, Z.U.H.; Khan, F.U. Biodirected synthesis of palladium nanoparticles using Phoenix dactylifera leaves extract and their size dependent biomedical and catalytic applications. RSC Adv. 2016, 6, 85903–85916. [Google Scholar] [CrossRef]
- Liu, T.Z.; Le, S.D.; Bhatnagar, R.S. Toxicity of palladium. Toxicol. Lett. 1979, 4, 469–473. [Google Scholar] [CrossRef]

Publisher’s Note: MDPI stays neutral with regard to jurisdictional claims in published maps and institutional affiliations. |
© 2021 by the authors. Licensee MDPI, Basel, Switzerland. This article is an open access article distributed under the terms and conditions of the Creative Commons Attribution (CC BY) license (http://creativecommons.org/licenses/by/4.0/).
Share and Cite
Mallikarjuna, K.; Nasif, O.; Ali Alharbi, S.; Chinni, S.V.; Reddy, L.V.; Reddy, M.R.V.; Sreeramanan, S. Phytogenic Synthesis of Pd-Ag/rGO Nanostructures Using Stevia Leaf Extract for Photocatalytic H2 Production and Antibacterial Studies. Biomolecules 2021, 11, 190. https://doi.org/10.3390/biom11020190
Mallikarjuna K, Nasif O, Ali Alharbi S, Chinni SV, Reddy LV, Reddy MRV, Sreeramanan S. Phytogenic Synthesis of Pd-Ag/rGO Nanostructures Using Stevia Leaf Extract for Photocatalytic H2 Production and Antibacterial Studies. Biomolecules. 2021; 11(2):190. https://doi.org/10.3390/biom11020190
Chicago/Turabian StyleMallikarjuna, Koduru, Omaima Nasif, Sulaiman Ali Alharbi, Suresh V. Chinni, Lebaka Veeranjaneya Reddy, Minnam Reddy Vasudeva Reddy, and Subramaniam Sreeramanan. 2021. "Phytogenic Synthesis of Pd-Ag/rGO Nanostructures Using Stevia Leaf Extract for Photocatalytic H2 Production and Antibacterial Studies" Biomolecules 11, no. 2: 190. https://doi.org/10.3390/biom11020190
APA StyleMallikarjuna, K., Nasif, O., Ali Alharbi, S., Chinni, S. V., Reddy, L. V., Reddy, M. R. V., & Sreeramanan, S. (2021). Phytogenic Synthesis of Pd-Ag/rGO Nanostructures Using Stevia Leaf Extract for Photocatalytic H2 Production and Antibacterial Studies. Biomolecules, 11(2), 190. https://doi.org/10.3390/biom11020190

